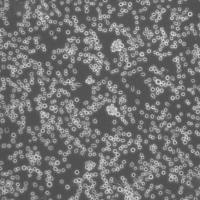
Panc 05.04 Cells人胰腺癌细胞库复苏传代|STR图谱

相关产品推荐更多 >
万千商家帮你免费找货
0 人在求购买到急需产品
- 详细信息
- 文献和实验
- 技术资料
- 品系:
详见细胞说明资料
- 细胞类型:
详见细胞说明资料
- 肿瘤类型:
详见细胞说明资料
- 供应商:
上海冠导生物工程有限公司
- 库存:
≥100瓶
- 生长状态:
详见细胞说明资料
- 年限:
详见细胞说明资料
- 运输方式:
常温运输【复苏细胞】或干冰运输【冻存细胞】
- 器官来源:
详见细胞说明资料
- 是否是肿瘤细胞:
详见细胞说明资料
- 细胞形态:
详见细胞说明资料
- 免疫类型:
详见细胞说明资料
- 物种来源:
详见细胞说明资料
- 相关疾病:
详见细胞说明资料
- 组织来源:
详见细胞说明资料
- 英文名:
MOLM-13人急性髓性白血病传代细胞|送STR图谱
- 规格:
1*10(6)Cellls/瓶
"MOLM-13人急性髓性白血病传代细胞|送STR图谱
传代方法:1:2-1:4(首次传代建议1:2)
生长特性:悬浮生长
换液频率:每周2-3次
背景资料:详见相关文献介绍
细胞系的选择需要考虑到细胞系的功能特点、生长速率、铺板效率、生长条件和生长特征、克隆效率、培养方式等因素,如果您想高产量表达重组蛋白,您可以选择可以悬浮生长的快速生长细胞系。细胞培养的操作步骤主要包括传代、换液、冻存和复苏。这些步骤确保了细胞能够在实验室环境中长期存活并继续增殖。传代是将细胞从一个容器转移到另一个容器的过程,以扩大细胞数量;换液是为了清除代谢废物并补充新鲜培养基;冻存则是为了长期保存细胞,而复苏则是重新激活冷冻保存的细胞使其恢复正常生长。
┈订┈购┈热┈线:1┈5┈8┈0┈0┈5┈7┈6┈8┈6┈7【微信同号】┈Q┈Q:3┈3┈0┈7┈2┈0┈4┈2┈7┈1;
NCIH660 Cells;背景说明:详见相关文献介绍;传代方法:2-3天换液1次。;生长特性:悬浮生长;形态特性:上皮细胞;相关产品有:UCLA-SO-14 Cells、UM-RC-2 Cells、KAT5 Cells
CoC1 Cells;背景说明:详见相关文献介绍;传代方法:1:2传代;生长特性:贴壁生长 ;形态特性:详见产品说明书;相关产品有:D324 Cells、L540 Cells、74Int Cells
Hs 852.T Cells;背景说明:详见相关文献介绍;传代方法:1:2-1:3传代;每周换液2-3次。;生长特性:贴壁生长;形态特性:上皮细胞;相关产品有:IR 983F Cells、HS852.T Cells、NTC-200 Cells
2164G7 Cells(拥有STR基因鉴定图谱)
MOLM-13人急性髓性白血病传代细胞|送STR图谱
产品包装形式:复苏细胞:T25培养瓶(一瓶)或冻存细胞:1ml冻存管(两支)
来源说明:细胞主要来源ATCC、DSMZ等细胞库
ATCC细胞库(American Type Culture Colection),该中心一直致力于细胞分类、鉴定和保藏工作。ATCC是全球最大的生物资源保藏中心,ATCC通过行业标准产品、服务和创新解决方案支持全球学术、政府、生物技术、制药、食品、农业和工业领域的科学进步。ATCC提供的服务和定制解决方案包括细胞和微生物培养、鉴定、生物衍生物的开发和生产、性能测试和生物资源保藏服务。美国国家标准协会(ANSI)认可了ATCC标准开发组织,并制定了标准协议,以确保生物材料的可靠性和可重复性。ATCC的使命是为了获取、鉴定、保存、开发、标准化和分发生物资源和生物信息,以提高和应用生物科学知识。
物种来源:Human\Mouse\Rat\Others
MOLM-13人急性髓性白血病传代细胞|送STR图谱
┈订┈购┈热┈线:1┈5┈8┈0┈0┈5┈7┈6┈8┈6┈7【微信同号】┈Q┈Q:3┈3┈0┈7┈2┈0┈4┈2┈7┈1;
ID8/MOSEC Cells;背景说明:详见相关文献介绍;传代方法:1:2传代;生长特性:贴壁生长 ;形态特性:详见产品说明书;相关产品有:QGP1 Cells、NCIN87 Cells、ADR-RES Cells
FLC7 Cells;背景说明:详见相关文献介绍;传代方法:1:2-1:3传代;每周换液2-3次。;生长特性:贴壁或悬浮,详见产品说明书部分;形态特性:详见产品说明书;相关产品有:GM00346B Cells、OVCAR8 Cells、Nb2 Cells
A-704 Cells;背景说明:详见相关文献介绍;传代方法:1:3—1:4传代,每周换液2-3次;生长特性:贴壁生长;形态特性:上皮细胞样;相关产品有:CEM C7 Cells、HCV29 Cells、NCI-H676B Cells
形态特性:淋巴母细胞样
细胞复苏相关注意事项:1.取细胞的过程中注意带HAO防冻手套,护目镜。此项尤为重要,细胞冻存管可能漏入,解冻时冻存管中的气温急剧上升,可导致爆炸。2.冻存的问题:冻存的配置已是常识,在这里不作详述,但二甲基亚砜(DMSO )对细胞不是完全无毒副作用,在常温下,二甲基亚砜对细胞的毒副作较大,因此,必须在1-2min内使冻存完全融化。如果复苏温度太慢,会造成细胞的损伤,二甲基亚砜(DMSO)ZuiHAO选择进口产品。3.离心前须加入少量培养。细胞解冻后二甲基亚砜浓度较GAO,注意加入少量培养可稀释其浓度,以减少对细胞的损伤。4.离心问题:目前主要有两种见解。一种是解冻后的细胞悬直接吹打均匀后分装到培养瓶中进行培养,第二天换。因为离心的目的是两个,去除DMSO,去除死细胞,这个是标准流程,但对一般人来说,把握不HAO离心转速和时间,转的不够活细胞沉底的少,细胞就全被扔掉了,转过了活细胞会受压过大,死亡。此外在操作过程中容易污染,所以不推荐。另一种说法为细胞悬中含有二甲基亚砜(DMSO),DMSO对细胞有一定的毒副作用,所以须将离心后的体前倒净,且一定倒干净。我在试验中按照常规的离心分装的方法进行复苏,结果无异常。5.细胞贴壁少的问题:教科书中说明冻存细胞解冻时1ml细胞要加10ml-15ml培养,而在我的试验中的经验总结为培养基越少细胞越容易贴附。6.复苏细胞分装的问题:试验中我的经验总结为复苏1管细胞一般可分装到1-2只培养瓶中,分装过多,细胞浓度过低,不利于细胞的贴壁。7.加培养基的量放入问题:这个量的多少的把握主要涉及到的问题DMSO的浓度,从如果你加培养基的太少,那么DMSO的浓度就会比较大,就会影响细胞生长,从以前的资料来看,DMSO的浓度在小于0.5%的时候对一般细胞没有什么影响,还有一个说法是1%。所以如果你的冻存的浓度是10%DMSO的话那么加10ml以上的培养基就恰HAO稀释到了无害浓度。
HONE-1 Cells;背景说明:鼻咽癌;男性;传代方法:1:2-1:3传代;每周换液2-3次。;生长特性:贴壁;形态特性:详见产品说明书;相关产品有:PG-4 S+L- Cells、GM05372E Cells、H1522 Cells
NUGC3 Cells;背景说明:详见相关文献介绍;传代方法:1:6传代;生长特性:贴壁生长;形态特性:上皮样;相关产品有:VMRC-RCZ Cells、SU-DHL6 Cells、16-HBEo Cells
COV 504 Cells;背景说明:详见相关文献介绍;传代方法:1:2传代;生长特性:贴壁生长;形态特性:上皮细胞;相关产品有:HGBEC Cells、NCI-H520 Cells、L-132 Cells
COR L279 Cells;背景说明:详见相关文献介绍;传代方法:1:2-1:3传代;每周换液2-3次。;生长特性:贴壁或悬浮,详见产品说明书部分;形态特性:详见产品说明书;相关产品有:LAN-1 Cells、BLO 11 Cells、MDA-157 Cells
CF-PAC1 Cells;背景说明:详见相关文献介绍;传代方法:1:3-10传代;2-3天换液1次。;生长特性:贴壁生长;形态特性:上皮细胞;相关产品有:NCIH2452 Cells、P30/Ohkubo Cells、NCC-IT Cells
HGBEC Cells;背景说明:详见相关文献介绍;传代方法:1:2-1:3传代;每周换液2-3次。;生长特性:贴壁或悬浮,详见产品说明书部分;形态特性:详见产品说明书;相关产品有:BEAS-2B Cells、MGH-U1 (EJ) Cells、LNCaP C4-2B Cells
T/G HA VSMC Cells;背景说明:详见相关文献介绍;传代方法:1:2-1:3传代;每周换液2-3次。;生长特性:贴壁或悬浮,详见产品说明书部分;形态特性:详见产品说明书;相关产品有:10T1/2 Cells、AsPC-1 Cells、HARAB Cells
H498 Cells;背景说明:结肠腺癌;男性;传代方法:1:2-1:3传代;每周换液2-3次。;生长特性:半贴壁;形态特性:详见产品说明书;相关产品有:MES-23.5 Cells、NCI-H676 Cells、Mel-MeWo Cells
JJN3 Cells;背景说明:详见相关文献介绍;传代方法:1:2-1:3传代;每周换液2-3次。;生长特性:贴壁或悬浮,详见产品说明书部分;形态特性:详见产品说明书;相关产品有:DrG Cells、SK-RC 39 Cells、MiaPaca.2 Cells
NK-10A Cells;背景说明:1967年,该细胞系KleinE和KleinG建系,源于一名16岁患有Burkitt's淋巴瘤的黑人男性,beta-2-微球蛋白阴性,表达EBNA,VCA,sIg。该细胞携带EB病毒,是一个典型的B淋巴母细胞系,可用于白血病发病机制的研究。;传代方法:1:2传代;生长特性:悬浮生长;形态特性:淋巴母细胞样;相关产品有:X63 Cells、EFO 27 Cells、LL/2(LLc1) Cells
BEAS 2B Cells;背景说明:从一位非癌个体的正常人支气管上皮病理切片分离出上皮细胞。这些细胞用腺病毒12-SV40病毒杂交病毒感染并克隆。DEAS-2B细胞保留了对血清反应进行鳞关分化的能力,并有用于筛选诱导或影响分化及致癌的化学或生物制剂。细胞角蛋白及SV40抗原染色阳性。;传代方法:消化3-5分钟。1:2。3天内可长满;生长特性:贴壁生长;形态特性:上皮细胞样;相关产品有:NTERA-2 Cells、MM1.S Cells、NCI-HUT-125 Cells
COLO 357 Cells;背景说明:胰腺癌;女性;传代方法:1:2-1:3传代;每周换液2-3次。;生长特性:贴壁;形态特性:详见产品说明书;相关产品有:MB-49 Cells、PC 61-5-3 Cells、AR42J Cells
C8D1A Cells;背景说明:该永生化细胞系源自出生8天小鼠小脑组织,由B Pessac, D Trisler建立。该细胞具有小神经胶质细胞特征。该细胞为GFAP阳性细胞,除此之外,没有检测到其它神经胶质神经元或小神经胶质细胞的分子标记。;传代方法:1:2传代;生长特性:贴壁生长 ;形态特性:详见产品说明书;相关产品有:NCIH1930 Cells、HELA-GFP Cells、Dunn LM8 Cells
GM01232E Cells;背景说明:1971年1月,该细胞由ReidTW及其同事从病人右眼切除的肿瘤进行原代培养建立而成,此病人有很强的视网膜母细胞瘤的母系家族遗传性。该细胞的超微结构,如核膜内折、三层膜结构、大的被膜小泡、环孔板、微管、中心粒、基粒等都与原始肿瘤相似。;传代方法:1:2传代;生长特性:悬浮生长;形态特性:圆形,成簇生长;相关产品有:P3.times.63 Ag8.653 Cells、CATH.a Cells、RS 4;11 Cells
MOLT4 Cells;背景说明:MOLT-4与MOLT-3来源于一名19岁的男性急性淋巴细胞性白血病的复发患者,该患者前期接受过多种药物联合化疗。MOLT-4细胞系为T淋巴细胞起源,p53基因的第248位密码子有一个G→A突变,不表达p53,不表达免疫球蛋白或EB病毒;可产生高水平的末端脱氧核糖转移酶;表达CD1(49%),CD2(35%),CD3A(26%)B(33%)C(34%),CD4(55%),CD5(72%),CD6(22%),CD7(77%)。;传代方法:1:2传代;生长特性:悬浮生长;形态特性:淋巴母细胞样;圆形;相关产品有:HME-1 Cells、VeroE6 Cells、Medical University of Graz-Chordoma 1 Cells
H747 Cells;背景说明:详见相关文献介绍;传代方法:1:2—1:4传代,每周换液2次;生长特性:贴壁生长;形态特性:上皮样;相关产品有:SUD-4 Cells、MDA MB 231 Cells、SUM-52PE Cells
Hs 822.T Cells;背景说明:详见相关文献介绍;传代方法:1:2-1:4传代;每周换液2-3次。;生长特性:贴壁生长;形态特性:上皮样;相关产品有:SK-N-MC Cells、CV 1 Cells、GCT0404 Cells
A-2984 Cells(拥有STR基因鉴定图谱)
Abcam MCF-7 NTRK2 KO Cells(拥有STR基因鉴定图谱)
AZ-H3c Cells(拥有STR基因鉴定图谱)
BayGenomics ES cell line RRO367 Cells(拥有STR基因鉴定图谱)
BayGenomics ES cell line YHB433 Cells(拥有STR基因鉴定图谱)
Cdelta2+ Cells(拥有STR基因鉴定图谱)
DA01178 Cells(拥有STR基因鉴定图谱)
┈订┈购┈热┈线:1┈5┈8┈0┈0┈5┈7┈6┈8┈6┈7【微信同号】┈Q┈Q:3┈3┈0┈7┈2┈0┈4┈2┈7┈1;
DA05701 Cells(拥有STR基因鉴定图谱)
GLC-4/CDDP11 Cells(拥有STR基因鉴定图谱)
Roswell Park Memorial Institute 7666 Cells;背景说明:详见相关文献介绍;传代方法:1:2-1:3传代;每周换液2-3次。;生长特性:贴壁或悬浮,详见产品说明书部分;形态特性:详见产品说明书;相关产品有:G-Olig2 Cells、Centre Antoine Lacassagne-85-1 Cells、Wistar Institute-38 Cells
LK2 Cells;背景说明:肺鳞癌;男性;传代方法:1:2-1:3传代;每周换液2-3次。;生长特性:贴壁;形态特性:详见产品说明书;相关产品有:H3396 Cells、PaTu 8988 S Cells、PC-3M 2B4 Cells
CHP 126 Cells;背景说明:详见相关文献介绍;传代方法:1:2-1:3传代;每周换液2-3次。;生长特性:贴壁或悬浮,详见产品说明书部分;形态特性:详见产品说明书;相关产品有:H-23 Cells、OVCAR.3 Cells、Cates-1B Cells
MOLM-13人急性髓性白血病传代细胞|送STR图谱
ECC-10 Cells;背景说明:详见相关文献介绍;传代方法:1:2传代;生长特性:贴壁或悬浮,详见产品说明书部分;形态特性:详见产品说明书;相关产品有:LICR-LON-HN6-R Cells、Z138 Cells、MDA-MB436 Cells
Doubling time: ~50 hours (ATCC). Cells;背景说明:详见相关文献介绍;传代方法:1:2-1:3传代;每周换液2-3次。;生长特性:贴壁或悬浮,详见产品说明书部分;形态特性:详见产品说明书;相关产品有:OV1/P Cells、HFL Cells、RBSMC Cells
H157 Cells;背景说明:详见相关文献介绍;传代方法:1:2传代;生长特性:贴壁生长 ;形态特性:详见产品说明书;相关产品有:CCRF-CEM C1 Cells、NCIH1048 Cells、NCIH841 Cells
SJ-Rh 30 Cells;背景说明:肺泡横纹肌肉瘤;骨髓转移;传代方法:1:2-1:3传代;每周换液2-3次。;生长特性:贴壁;形态特性:详见产品说明书;相关产品有:LLC PK1 Cells、H716 Cells、RKN Cells
Hs-578T Cells;背景说明:详见相关文献介绍;传代方法:1:2-1:3传代;每周换液2-3次。;生长特性:贴壁或悬浮,详见产品说明书部分;形态特性:详见产品说明书;相关产品有:MV411 Cells、SGC-996 Cells、H-2126 Cells
CV-1 in Origin Simian-1 Cells;背景说明:该细胞源自CV-1细胞株,经转染编码野生型T抗原、起始点缺陷突变的SV40得到;细胞中整合有SV40基因组完整早期区段的单个拷贝。该细胞表达T抗原,适用于需要SV40T抗原表达的载体的转染;保留SV40溶细胞性生长的特性;支持40℃时温度敏感性A209病毒的复制;支持早期区段缺失的SV40纯体的复制。因含有SV40的DNA序列,该细胞需要在2级生物安全柜中操作。;传代方法:1:2传代;生长特性:贴壁生长;形态特性:成纤维细胞样;相关产品有:H-1993 Cells、PG-4 (S+L-) Cells、TF-1a Cells
GCT0404 Cells;背景说明:骨巨细胞瘤;传代方法:1:2-1:3传代;每周换液2-3次。;生长特性:贴壁;形态特性:详见产品说明书;相关产品有:HS766T Cells、Roswell Park Memorial Institute 1788 Cells、SL1 Cells
E.G7-OVA Cells;背景说明:详见相关文献介绍;传代方法:细胞密度保持在1×105—1×106 cells/ml,每周换液2—3次 ;生长特性:悬浮生长;形态特性:详见产品说明书;相关产品有:EOC20 Cells、CAKI 1 Cells、AD-293 Cells
HTR-8/SVneo Cells;背景说明:详见相关文献介绍;传代方法:1:2-1:3传代;每周换液2-3次。;生长特性:贴壁;形态特性:上皮细胞样;相关产品有:DV-90 Cells、hCMEC/D3 Cells、PC-12 Cells
18G3.cl 1 Cells;背景说明:详见相关文献介绍;传代方法:1:2-1:3传代;每周换液2-3次。;生长特性:贴壁或悬浮,详见产品说明书部分;形态特性:详见产品说明书;相关产品有:SNU-216 Cells、NCI H157 Cells、SKGIIIA Cells
Kupffer Cells;背景说明:详见相关文献介绍;传代方法:1:2-1:3传代;每周换液2-3次。;生长特性:贴壁;形态特性:详见产品说明书;相关产品有:Hs-729-T Cells、HN 4 Cells、SUM 190PT Cells
SP-2 Cells;背景说明:该细胞是由绵羊红细胞免疫的BALB/c小鼠脾细胞和P3X63Ag8骨髓瘤细胞融合得到的。该细胞不分泌免疫球蛋白,对20μg/ml的8-氮鸟嘌呤有抗性,对HAT比较敏感;该细胞可以作为细胞融合时的B细胞组分用于制备杂交瘤;鼠痘病毒阴性。;传代方法:1:2传代;生长特性:悬浮生长;形态特性:淋巴母细胞样;圆形;相关产品有:FBHE Cells、U-226AR1 Cells、BNL 1ME A.7R.1 Cells
HAM013 Cells(拥有STR基因鉴定图谱)
HAP1 RYBP (-) 1 Cells(拥有STR基因鉴定图谱)
TEV-1 Cells;背景说明:滋养层;传代方法:1:2-1:3传代;每周换液2-3次。;生长特性:贴壁;形态特性:详见产品说明书;相关产品有:4175 Cells、Pan02 Cells、Normal fibroblast-10 Cells
Hs-274-T Cells;背景说明:详见相关文献介绍;传代方法:1:2传代,每周换液2-3次。;生长特性:贴壁生长;形态特性:成纤维细胞;相关产品有:GI-1 Cells、HeLa S-3 Cells、Pfeiffer Cells
VMCUB-1 Cells;背景说明:详见相关文献介绍;传代方法:1:2-1:3传代;每周换液2-3次。;生长特性:贴壁或悬浮,详见产品说明书部分;形态特性:详见产品说明书;相关产品有:Huh 7.5.1 Cells、NB1RGB Cells、NOR10 Cells
Huh-7 Cells;背景说明:详见相关文献介绍;传代方法:消化3-5分钟。1:2。3天内可长满。;生长特性:贴壁生长;形态特性:上皮样;相关产品有:MCM Cells、EAhy926 Cells、MDAMB435S Cells
LO2 Cells;背景说明:详见相关文献介绍;传代方法:1:2-1:3传代;每周换液2-3次。;生长特性:贴壁或悬浮,详见产品说明书部分;形态特性:详见产品说明书;相关产品有:IOSE 29 Cells、NR 8383 Cells、Hs 695T Cells
SNU-423 Cells;背景说明:详见相关文献介绍;传代方法:1:2传代;生长特性:贴壁生长;形态特性:上皮样;相关产品有:CNE-2 Cells、SRA01/04 (HLE) Cells、CTLA4 Ig-24 Cells
Ly19 Cells;背景说明:弥漫大B淋巴瘤;女性;传代方法:1:2-1:3传代;每周换液2-3次。;生长特性:悬浮;形态特性:详见产品说明书;相关产品有:CRFK Cells、SuperTube Cells、NB9 Cells
SW579 Cells;背景说明:在裸鼠中成瘤(产生三级恶性纺锤状巨细胞瘤)。 ;传代方法:1:2传代;生长特性:贴壁生长;形态特性:上皮细胞样;相关产品有:Human ErythroLeukemia Cells、HS766T Cells、Ej138 Cells
HyCyte Bewo KO-hABCG2 Cells(拥有STR基因鉴定图谱)
LB2784-MEL Cells(拥有STR基因鉴定图谱)
MyLa 1928 Cells(拥有STR基因鉴定图谱)
OUMS-22 [1972] Cells(拥有STR基因鉴定图谱)
RPMI-7722 Cells(拥有STR基因鉴定图谱)
Ubigene A-549 CACNG4 KO Cells(拥有STR基因鉴定图谱)
UOFS-CT-1 Cells(拥有STR基因鉴定图谱)
HAP1 USP15 (-) 3 Cells(拥有STR基因鉴定图谱)
PECAPJ34 Cells;背景说明:详见相关文献介绍;传代方法:1:2传代;生长特性:贴壁生长;形态特性:上皮样;相关产品有:BT Cells、C518 Cells、Hs611T Cells
SRA 01/04 Cells;背景说明:晶状体;上皮细胞;SV40转化;男性;传代方法:1:2-1:3传代;每周换液2-3次。;生长特性:贴壁;形态特性:详见产品说明书;相关产品有:HN4 Cells、CEM-0 Cells、MC38 Cells
253J B-V Cells;背景说明:膀胱癌;淋巴结转移;男性;传代方法:1:2-1:3传代;每周换液2-3次。;生长特性:贴壁;形态特性:详见产品说明书;相关产品有:MNNG/HOS Cl #5 Cells、HEC-1A Cells、H838 Cells
BIC1 Cells;背景说明:食管腺癌;男性;传代方法:1:2-1:3传代;每周换液2-3次。;生长特性:贴壁;形态特性:详见产品说明书;相关产品有:NCI-H1048 Cells、TR 146 Cells、AHH-1 Cells
COLO-699 Cells;背景说明:详见相关文献介绍;传代方法:1:2-1:3传代;每周换液2-3次。;生长特性:贴壁或悬浮,详见产品说明书部分;形态特性:详见产品说明书;相关产品有:LI7 Cells、CMT-64 Cells、BSC-1 Cells
COLO-699 Cells;背景说明:详见相关文献介绍;传代方法:1:2-1:3传代;每周换液2-3次。;生长特性:贴壁或悬浮,详见产品说明书部分;形态特性:详见产品说明书;相关产品有:LI7 Cells、CMT-64 Cells、BSC-1 Cells
TE354.T Cells;背景说明:详见相关文献介绍;传代方法:1:2传代;生长特性:贴壁生长 ;形态特性:详见产品说明书;相关产品有:S.B. Cells、HCC44 Cells、RS1 Cells
Medical University of Graz-Chordoma 1 Cells;背景说明:骶骨脊索瘤;女性;传代方法:1:2-1:3传代;每周换液2-3次。;生长特性:贴壁;形态特性:详见产品说明书;相关产品有:HEH2 Cells、CA46 Cells、B95-8 Cells
Gejiu Lung Carcinoma-82 Cells;背景说明:详见相关文献介绍;传代方法:1:2-1:3传代;每周换液2-3次。;生长特性:贴壁或悬浮,详见产品说明书部分;形态特性:详见产品说明书;相关产品有:NCI-H1395 Cells、87 MG Cells、OCILY-3 Cells
H-2108 Cells;背景说明:详见相关文献介绍;传代方法:1:2-1:3传代;每周换液2-3次。;生长特性:贴壁或悬浮,详见产品说明书部分;形态特性:详见产品说明书;相关产品有:HEK;293 Cells、KM932 Cells、HS578 Cells
Cor L51 Cells;背景说明:详见相关文献介绍;传代方法:1:2-1:3传代;每周换液2-3次。;生长特性:贴壁或悬浮,详见产品说明书部分;形态特性:详见产品说明书;相关产品有:NU-GC-3 Cells、8305C Cells、MeSoTheliOma-211H Cells
CORL23 Cells;背景说明:详见相关文献介绍;传代方法:1:2-1:3传代;每周换液2-3次。;生长特性:贴壁或悬浮,详见产品说明书部分;形态特性:详见产品说明书;相关产品有:DoTc2 Cells、Madin Darby Bovine Kidney Cells、RF/6A Cells
HCT/FU Cells;背景说明:详见相关文献介绍;传代方法:1:2-1:3传代;每周换液2-3次。;生长特性:贴壁或悬浮,详见产品说明书部分;形态特性:详见产品说明书;相关产品有:Hs 27 Cells、Panc-1-P Cells、HUVSMC Cells
C3H10T1-2 Cells;背景说明:详见相关文献介绍;传代方法:1:2-1:3传代;每周换液2-3次。;生长特性:贴壁或悬浮,详见产品说明书部分;形态特性:详见产品说明书;相关产品有:V79-1 Cells、BT 325 Cells、Stanford University-Diffuse Histiocytic Lymphoma-5 Cells
YD-15 Cells;背景说明:舌鳞癌;男性;传代方法:1:2-1:3传代;每周换液2-3次。;生长特性:贴壁;形态特性:详见产品说明书;相关产品有:Ketr3 Cells、NSC34 Cells、Panc-10.05 Cells
TC-1/dB2m Cells(拥有STR基因鉴定图谱)
CEM/0 Cells;背景说明:G.E. Foley 等人建立了类淋巴母细胞细胞株CCRF-CEM。 细胞是1964年11月从一位四岁白人女性急性淋巴细胞白血病患者的外周血白血球衣中得到。此细胞系从香港收集而来。;传代方法:1:2传代。3天内可长满。;生长特性:悬浮生长;形态特性:淋巴母细胞样;相关产品有:NCI-H1734 Cells、GM01232E Cells、NTera-2D1 Cells
Cates 1B Cells;背景说明:详见相关文献介绍;传代方法:1:2-1:3传代;每周换液2-3次。;生长特性:贴壁或悬浮,详见产品说明书部分;形态特性:详见产品说明书;相关产品有:KP2 Cells、67NR Cells、A549 Cells
H-2342 Cells;背景说明:详见相关文献介绍;传代方法:1:2-1:6传代 ;生长特性:贴壁生长;形态特性:上皮样;相关产品有:HCT116/L Cells、LoVo Cells、H1563 Cells
B16 melanoma Cells;背景说明:该细胞源于C57BL/6J小鼠黑色素瘤,可以产生黑色素,同基因小鼠体内移植可成瘤;传代方法:1:3传代,2-3天换液一次;生长特性:贴壁生长;形态特性:梭形;相关产品有:As-PC1 Cells、End1/E6E7 Cells、H889 Cells
XuanWei Lung Cancer-05 Cells;背景说明:肺癌;女性;传代方法:1:2-1:3传代;每周换液2-3次。;生长特性:贴壁;形态特性:详见产品说明书;相关产品有:GM 2132 Cells、MFE 280 Cells、R D Cells
┈订┈购┈热┈线:1┈5┈8┈0┈0┈5┈7┈6┈8┈6┈7【微信同号】┈Q┈Q:3┈3┈0┈7┈2┈0┈4┈2┈7┈1;
T2 Cells;背景说明:详见相关文献介绍;传代方法:1:3—1:6传代,每周换液2—3次;生长特性:悬浮生长;形态特性:淋巴母细胞样;相关产品有:HCC-38 Cells、Mel-624 Cells、Hs-695-T Cells
LN 229 Cells;背景说明:详见相关文献介绍;传代方法:1:4-1:6传代;每周换液2-3次;生长特性:贴壁生长;形态特性:上皮细胞;相关产品有:RBMVEC Cells、SUM 52PE Cells、COLO-679 Cells
SB Cells;背景说明:急性T淋巴细胞白血病;男性;传代方法:1:2-1:3传代;每周换液2-3次。;生长特性:悬浮;形态特性:详见产品说明书;相关产品有:SU8686 Cells、KG-1 Cells、Tu 177 Cells
Eca-109 Cells;背景说明:1973年建系,来自人食管中段鳞癌组织,小块法原代培养建系。BALB/c裸鼠移植成瘤。;传代方法:1:2-1:3传代;每周换液2-3次。;生长特性:贴壁;形态特性:上皮细胞样;相关产品有:SKMEL1 Cells、F-36P Cells、HCMEC(BL12-H) Cells
MOLM-13人急性髓性白血病传代细胞|送STR图谱
TFK1 Cells;背景说明:胆管癌;男性;传代方法:1:2-1:3传代;每周换液2-3次。;生长特性:贴壁;形态特性:详见产品说明书;相关产品有:ID8 Cells、Kasumi 1 Cells、HSC Cells
SMMC-7721 Cells;背景说明:用Northernblot方法,未能检测到细胞中1.3kbLFIRE-1/HFREP-1mRNA的表达。;传代方法:1:3传代,2-3天换液一次;生长特性:贴壁生长;形态特性:上皮样;相关产品有:CCD841CoN Cells、OCILY3 Cells、MODE-K Cells
MeWo Cells;背景说明:详见相关文献介绍;传代方法:1:3-1:5传代,2-3天换液1次。;生长特性:混合生长;形态特性:成纤维细胞;相关产品有:OCI-Ly3 Cells、87 MG Cells、OS-732 Cells
NRK clone 52E Cells;背景说明:详见相关文献介绍;传代方法:1:2传代;生长特性:贴壁生长;形态特性:上皮细胞样;相关产品有:CHOS Cells、KTA-7 Cells、B-3 Cells
M14 Cells;背景说明:详见相关文献介绍;传代方法:1:3传代;生长特性:混合生长;形态特性:详见产品说明书;相关产品有:LTEP-a-2 Cells、BALL1 Cells、L cell line Cells
BayGenomics ES cell line CSE033 Cells(拥有STR基因鉴定图谱)
BayGenomics ES cell line RRT164 Cells(拥有STR基因鉴定图谱)
BayGenomics ES cell line YTC336 Cells(拥有STR基因鉴定图谱)
IX-5H9-C10 Cells(拥有STR基因鉴定图谱)
PCRP-TCF24-1D6 Cells(拥有STR基因鉴定图谱)
LO-MK-1 Cells(拥有STR基因鉴定图谱)
"
传代方法:1:2-1:4(首次传代建议1:2)
生长特性:悬浮生长
换液频率:每周2-3次
背景资料:详见相关文献介绍
细胞系的选择需要考虑到细胞系的功能特点、生长速率、铺板效率、生长条件和生长特征、克隆效率、培养方式等因素,如果您想高产量表达重组蛋白,您可以选择可以悬浮生长的快速生长细胞系。细胞培养的操作步骤主要包括传代、换液、冻存和复苏。这些步骤确保了细胞能够在实验室环境中长期存活并继续增殖。传代是将细胞从一个容器转移到另一个容器的过程,以扩大细胞数量;换液是为了清除代谢废物并补充新鲜培养基;冻存则是为了长期保存细胞,而复苏则是重新激活冷冻保存的细胞使其恢复正常生长。
┈订┈购┈热┈线:1┈5┈8┈0┈0┈5┈7┈6┈8┈6┈7【微信同号】┈Q┈Q:3┈3┈0┈7┈2┈0┈4┈2┈7┈1;
NCIH660 Cells;背景说明:详见相关文献介绍;传代方法:2-3天换液1次。;生长特性:悬浮生长;形态特性:上皮细胞;相关产品有:UCLA-SO-14 Cells、UM-RC-2 Cells、KAT5 Cells
CoC1 Cells;背景说明:详见相关文献介绍;传代方法:1:2传代;生长特性:贴壁生长 ;形态特性:详见产品说明书;相关产品有:D324 Cells、L540 Cells、74Int Cells
Hs 852.T Cells;背景说明:详见相关文献介绍;传代方法:1:2-1:3传代;每周换液2-3次。;生长特性:贴壁生长;形态特性:上皮细胞;相关产品有:IR 983F Cells、HS852.T Cells、NTC-200 Cells
2164G7 Cells(拥有STR基因鉴定图谱)
MOLM-13人急性髓性白血病传代细胞|送STR图谱
产品包装形式:复苏细胞:T25培养瓶(一瓶)或冻存细胞:1ml冻存管(两支)
来源说明:细胞主要来源ATCC、DSMZ等细胞库
ATCC细胞库(American Type Culture Colection),该中心一直致力于细胞分类、鉴定和保藏工作。ATCC是全球最大的生物资源保藏中心,ATCC通过行业标准产品、服务和创新解决方案支持全球学术、政府、生物技术、制药、食品、农业和工业领域的科学进步。ATCC提供的服务和定制解决方案包括细胞和微生物培养、鉴定、生物衍生物的开发和生产、性能测试和生物资源保藏服务。美国国家标准协会(ANSI)认可了ATCC标准开发组织,并制定了标准协议,以确保生物材料的可靠性和可重复性。ATCC的使命是为了获取、鉴定、保存、开发、标准化和分发生物资源和生物信息,以提高和应用生物科学知识。
物种来源:Human\Mouse\Rat\Others
MOLM-13人急性髓性白血病传代细胞|送STR图谱
┈订┈购┈热┈线:1┈5┈8┈0┈0┈5┈7┈6┈8┈6┈7【微信同号】┈Q┈Q:3┈3┈0┈7┈2┈0┈4┈2┈7┈1;
ID8/MOSEC Cells;背景说明:详见相关文献介绍;传代方法:1:2传代;生长特性:贴壁生长 ;形态特性:详见产品说明书;相关产品有:QGP1 Cells、NCIN87 Cells、ADR-RES Cells
FLC7 Cells;背景说明:详见相关文献介绍;传代方法:1:2-1:3传代;每周换液2-3次。;生长特性:贴壁或悬浮,详见产品说明书部分;形态特性:详见产品说明书;相关产品有:GM00346B Cells、OVCAR8 Cells、Nb2 Cells
A-704 Cells;背景说明:详见相关文献介绍;传代方法:1:3—1:4传代,每周换液2-3次;生长特性:贴壁生长;形态特性:上皮细胞样;相关产品有:CEM C7 Cells、HCV29 Cells、NCI-H676B Cells
形态特性:淋巴母细胞样
细胞复苏相关注意事项:1.取细胞的过程中注意带HAO防冻手套,护目镜。此项尤为重要,细胞冻存管可能漏入,解冻时冻存管中的气温急剧上升,可导致爆炸。2.冻存的问题:冻存的配置已是常识,在这里不作详述,但二甲基亚砜(DMSO )对细胞不是完全无毒副作用,在常温下,二甲基亚砜对细胞的毒副作较大,因此,必须在1-2min内使冻存完全融化。如果复苏温度太慢,会造成细胞的损伤,二甲基亚砜(DMSO)ZuiHAO选择进口产品。3.离心前须加入少量培养。细胞解冻后二甲基亚砜浓度较GAO,注意加入少量培养可稀释其浓度,以减少对细胞的损伤。4.离心问题:目前主要有两种见解。一种是解冻后的细胞悬直接吹打均匀后分装到培养瓶中进行培养,第二天换。因为离心的目的是两个,去除DMSO,去除死细胞,这个是标准流程,但对一般人来说,把握不HAO离心转速和时间,转的不够活细胞沉底的少,细胞就全被扔掉了,转过了活细胞会受压过大,死亡。此外在操作过程中容易污染,所以不推荐。另一种说法为细胞悬中含有二甲基亚砜(DMSO),DMSO对细胞有一定的毒副作用,所以须将离心后的体前倒净,且一定倒干净。我在试验中按照常规的离心分装的方法进行复苏,结果无异常。5.细胞贴壁少的问题:教科书中说明冻存细胞解冻时1ml细胞要加10ml-15ml培养,而在我的试验中的经验总结为培养基越少细胞越容易贴附。6.复苏细胞分装的问题:试验中我的经验总结为复苏1管细胞一般可分装到1-2只培养瓶中,分装过多,细胞浓度过低,不利于细胞的贴壁。7.加培养基的量放入问题:这个量的多少的把握主要涉及到的问题DMSO的浓度,从如果你加培养基的太少,那么DMSO的浓度就会比较大,就会影响细胞生长,从以前的资料来看,DMSO的浓度在小于0.5%的时候对一般细胞没有什么影响,还有一个说法是1%。所以如果你的冻存的浓度是10%DMSO的话那么加10ml以上的培养基就恰HAO稀释到了无害浓度。
HONE-1 Cells;背景说明:鼻咽癌;男性;传代方法:1:2-1:3传代;每周换液2-3次。;生长特性:贴壁;形态特性:详见产品说明书;相关产品有:PG-4 S+L- Cells、GM05372E Cells、H1522 Cells
NUGC3 Cells;背景说明:详见相关文献介绍;传代方法:1:6传代;生长特性:贴壁生长;形态特性:上皮样;相关产品有:VMRC-RCZ Cells、SU-DHL6 Cells、16-HBEo Cells
COV 504 Cells;背景说明:详见相关文献介绍;传代方法:1:2传代;生长特性:贴壁生长;形态特性:上皮细胞;相关产品有:HGBEC Cells、NCI-H520 Cells、L-132 Cells
COR L279 Cells;背景说明:详见相关文献介绍;传代方法:1:2-1:3传代;每周换液2-3次。;生长特性:贴壁或悬浮,详见产品说明书部分;形态特性:详见产品说明书;相关产品有:LAN-1 Cells、BLO 11 Cells、MDA-157 Cells
CF-PAC1 Cells;背景说明:详见相关文献介绍;传代方法:1:3-10传代;2-3天换液1次。;生长特性:贴壁生长;形态特性:上皮细胞;相关产品有:NCIH2452 Cells、P30/Ohkubo Cells、NCC-IT Cells
HGBEC Cells;背景说明:详见相关文献介绍;传代方法:1:2-1:3传代;每周换液2-3次。;生长特性:贴壁或悬浮,详见产品说明书部分;形态特性:详见产品说明书;相关产品有:BEAS-2B Cells、MGH-U1 (EJ) Cells、LNCaP C4-2B Cells
T/G HA VSMC Cells;背景说明:详见相关文献介绍;传代方法:1:2-1:3传代;每周换液2-3次。;生长特性:贴壁或悬浮,详见产品说明书部分;形态特性:详见产品说明书;相关产品有:10T1/2 Cells、AsPC-1 Cells、HARAB Cells
H498 Cells;背景说明:结肠腺癌;男性;传代方法:1:2-1:3传代;每周换液2-3次。;生长特性:半贴壁;形态特性:详见产品说明书;相关产品有:MES-23.5 Cells、NCI-H676 Cells、Mel-MeWo Cells
JJN3 Cells;背景说明:详见相关文献介绍;传代方法:1:2-1:3传代;每周换液2-3次。;生长特性:贴壁或悬浮,详见产品说明书部分;形态特性:详见产品说明书;相关产品有:DrG Cells、SK-RC 39 Cells、MiaPaca.2 Cells
NK-10A Cells;背景说明:1967年,该细胞系KleinE和KleinG建系,源于一名16岁患有Burkitt's淋巴瘤的黑人男性,beta-2-微球蛋白阴性,表达EBNA,VCA,sIg。该细胞携带EB病毒,是一个典型的B淋巴母细胞系,可用于白血病发病机制的研究。;传代方法:1:2传代;生长特性:悬浮生长;形态特性:淋巴母细胞样;相关产品有:X63 Cells、EFO 27 Cells、LL/2(LLc1) Cells
BEAS 2B Cells;背景说明:从一位非癌个体的正常人支气管上皮病理切片分离出上皮细胞。这些细胞用腺病毒12-SV40病毒杂交病毒感染并克隆。DEAS-2B细胞保留了对血清反应进行鳞关分化的能力,并有用于筛选诱导或影响分化及致癌的化学或生物制剂。细胞角蛋白及SV40抗原染色阳性。;传代方法:消化3-5分钟。1:2。3天内可长满;生长特性:贴壁生长;形态特性:上皮细胞样;相关产品有:NTERA-2 Cells、MM1.S Cells、NCI-HUT-125 Cells
COLO 357 Cells;背景说明:胰腺癌;女性;传代方法:1:2-1:3传代;每周换液2-3次。;生长特性:贴壁;形态特性:详见产品说明书;相关产品有:MB-49 Cells、PC 61-5-3 Cells、AR42J Cells
C8D1A Cells;背景说明:该永生化细胞系源自出生8天小鼠小脑组织,由B Pessac, D Trisler建立。该细胞具有小神经胶质细胞特征。该细胞为GFAP阳性细胞,除此之外,没有检测到其它神经胶质神经元或小神经胶质细胞的分子标记。;传代方法:1:2传代;生长特性:贴壁生长 ;形态特性:详见产品说明书;相关产品有:NCIH1930 Cells、HELA-GFP Cells、Dunn LM8 Cells
GM01232E Cells;背景说明:1971年1月,该细胞由ReidTW及其同事从病人右眼切除的肿瘤进行原代培养建立而成,此病人有很强的视网膜母细胞瘤的母系家族遗传性。该细胞的超微结构,如核膜内折、三层膜结构、大的被膜小泡、环孔板、微管、中心粒、基粒等都与原始肿瘤相似。;传代方法:1:2传代;生长特性:悬浮生长;形态特性:圆形,成簇生长;相关产品有:P3.times.63 Ag8.653 Cells、CATH.a Cells、RS 4;11 Cells
MOLT4 Cells;背景说明:MOLT-4与MOLT-3来源于一名19岁的男性急性淋巴细胞性白血病的复发患者,该患者前期接受过多种药物联合化疗。MOLT-4细胞系为T淋巴细胞起源,p53基因的第248位密码子有一个G→A突变,不表达p53,不表达免疫球蛋白或EB病毒;可产生高水平的末端脱氧核糖转移酶;表达CD1(49%),CD2(35%),CD3A(26%)B(33%)C(34%),CD4(55%),CD5(72%),CD6(22%),CD7(77%)。;传代方法:1:2传代;生长特性:悬浮生长;形态特性:淋巴母细胞样;圆形;相关产品有:HME-1 Cells、VeroE6 Cells、Medical University of Graz-Chordoma 1 Cells
H747 Cells;背景说明:详见相关文献介绍;传代方法:1:2—1:4传代,每周换液2次;生长特性:贴壁生长;形态特性:上皮样;相关产品有:SUD-4 Cells、MDA MB 231 Cells、SUM-52PE Cells
Hs 822.T Cells;背景说明:详见相关文献介绍;传代方法:1:2-1:4传代;每周换液2-3次。;生长特性:贴壁生长;形态特性:上皮样;相关产品有:SK-N-MC Cells、CV 1 Cells、GCT0404 Cells
A-2984 Cells(拥有STR基因鉴定图谱)
Abcam MCF-7 NTRK2 KO Cells(拥有STR基因鉴定图谱)
AZ-H3c Cells(拥有STR基因鉴定图谱)
BayGenomics ES cell line RRO367 Cells(拥有STR基因鉴定图谱)
BayGenomics ES cell line YHB433 Cells(拥有STR基因鉴定图谱)
Cdelta2+ Cells(拥有STR基因鉴定图谱)
DA01178 Cells(拥有STR基因鉴定图谱)
┈订┈购┈热┈线:1┈5┈8┈0┈0┈5┈7┈6┈8┈6┈7【微信同号】┈Q┈Q:3┈3┈0┈7┈2┈0┈4┈2┈7┈1;
DA05701 Cells(拥有STR基因鉴定图谱)
GLC-4/CDDP11 Cells(拥有STR基因鉴定图谱)
Roswell Park Memorial Institute 7666 Cells;背景说明:详见相关文献介绍;传代方法:1:2-1:3传代;每周换液2-3次。;生长特性:贴壁或悬浮,详见产品说明书部分;形态特性:详见产品说明书;相关产品有:G-Olig2 Cells、Centre Antoine Lacassagne-85-1 Cells、Wistar Institute-38 Cells
LK2 Cells;背景说明:肺鳞癌;男性;传代方法:1:2-1:3传代;每周换液2-3次。;生长特性:贴壁;形态特性:详见产品说明书;相关产品有:H3396 Cells、PaTu 8988 S Cells、PC-3M 2B4 Cells
CHP 126 Cells;背景说明:详见相关文献介绍;传代方法:1:2-1:3传代;每周换液2-3次。;生长特性:贴壁或悬浮,详见产品说明书部分;形态特性:详见产品说明书;相关产品有:H-23 Cells、OVCAR.3 Cells、Cates-1B Cells
MOLM-13人急性髓性白血病传代细胞|送STR图谱
ECC-10 Cells;背景说明:详见相关文献介绍;传代方法:1:2传代;生长特性:贴壁或悬浮,详见产品说明书部分;形态特性:详见产品说明书;相关产品有:LICR-LON-HN6-R Cells、Z138 Cells、MDA-MB436 Cells
Doubling time: ~50 hours (ATCC). Cells;背景说明:详见相关文献介绍;传代方法:1:2-1:3传代;每周换液2-3次。;生长特性:贴壁或悬浮,详见产品说明书部分;形态特性:详见产品说明书;相关产品有:OV1/P Cells、HFL Cells、RBSMC Cells
H157 Cells;背景说明:详见相关文献介绍;传代方法:1:2传代;生长特性:贴壁生长 ;形态特性:详见产品说明书;相关产品有:CCRF-CEM C1 Cells、NCIH1048 Cells、NCIH841 Cells
SJ-Rh 30 Cells;背景说明:肺泡横纹肌肉瘤;骨髓转移;传代方法:1:2-1:3传代;每周换液2-3次。;生长特性:贴壁;形态特性:详见产品说明书;相关产品有:LLC PK1 Cells、H716 Cells、RKN Cells
Hs-578T Cells;背景说明:详见相关文献介绍;传代方法:1:2-1:3传代;每周换液2-3次。;生长特性:贴壁或悬浮,详见产品说明书部分;形态特性:详见产品说明书;相关产品有:MV411 Cells、SGC-996 Cells、H-2126 Cells
CV-1 in Origin Simian-1 Cells;背景说明:该细胞源自CV-1细胞株,经转染编码野生型T抗原、起始点缺陷突变的SV40得到;细胞中整合有SV40基因组完整早期区段的单个拷贝。该细胞表达T抗原,适用于需要SV40T抗原表达的载体的转染;保留SV40溶细胞性生长的特性;支持40℃时温度敏感性A209病毒的复制;支持早期区段缺失的SV40纯体的复制。因含有SV40的DNA序列,该细胞需要在2级生物安全柜中操作。;传代方法:1:2传代;生长特性:贴壁生长;形态特性:成纤维细胞样;相关产品有:H-1993 Cells、PG-4 (S+L-) Cells、TF-1a Cells
GCT0404 Cells;背景说明:骨巨细胞瘤;传代方法:1:2-1:3传代;每周换液2-3次。;生长特性:贴壁;形态特性:详见产品说明书;相关产品有:HS766T Cells、Roswell Park Memorial Institute 1788 Cells、SL1 Cells
E.G7-OVA Cells;背景说明:详见相关文献介绍;传代方法:细胞密度保持在1×105—1×106 cells/ml,每周换液2—3次 ;生长特性:悬浮生长;形态特性:详见产品说明书;相关产品有:EOC20 Cells、CAKI 1 Cells、AD-293 Cells
HTR-8/SVneo Cells;背景说明:详见相关文献介绍;传代方法:1:2-1:3传代;每周换液2-3次。;生长特性:贴壁;形态特性:上皮细胞样;相关产品有:DV-90 Cells、hCMEC/D3 Cells、PC-12 Cells
18G3.cl 1 Cells;背景说明:详见相关文献介绍;传代方法:1:2-1:3传代;每周换液2-3次。;生长特性:贴壁或悬浮,详见产品说明书部分;形态特性:详见产品说明书;相关产品有:SNU-216 Cells、NCI H157 Cells、SKGIIIA Cells
Kupffer Cells;背景说明:详见相关文献介绍;传代方法:1:2-1:3传代;每周换液2-3次。;生长特性:贴壁;形态特性:详见产品说明书;相关产品有:Hs-729-T Cells、HN 4 Cells、SUM 190PT Cells
SP-2 Cells;背景说明:该细胞是由绵羊红细胞免疫的BALB/c小鼠脾细胞和P3X63Ag8骨髓瘤细胞融合得到的。该细胞不分泌免疫球蛋白,对20μg/ml的8-氮鸟嘌呤有抗性,对HAT比较敏感;该细胞可以作为细胞融合时的B细胞组分用于制备杂交瘤;鼠痘病毒阴性。;传代方法:1:2传代;生长特性:悬浮生长;形态特性:淋巴母细胞样;圆形;相关产品有:FBHE Cells、U-226AR1 Cells、BNL 1ME A.7R.1 Cells
HAM013 Cells(拥有STR基因鉴定图谱)
HAP1 RYBP (-) 1 Cells(拥有STR基因鉴定图谱)
TEV-1 Cells;背景说明:滋养层;传代方法:1:2-1:3传代;每周换液2-3次。;生长特性:贴壁;形态特性:详见产品说明书;相关产品有:4175 Cells、Pan02 Cells、Normal fibroblast-10 Cells
Hs-274-T Cells;背景说明:详见相关文献介绍;传代方法:1:2传代,每周换液2-3次。;生长特性:贴壁生长;形态特性:成纤维细胞;相关产品有:GI-1 Cells、HeLa S-3 Cells、Pfeiffer Cells
VMCUB-1 Cells;背景说明:详见相关文献介绍;传代方法:1:2-1:3传代;每周换液2-3次。;生长特性:贴壁或悬浮,详见产品说明书部分;形态特性:详见产品说明书;相关产品有:Huh 7.5.1 Cells、NB1RGB Cells、NOR10 Cells
Huh-7 Cells;背景说明:详见相关文献介绍;传代方法:消化3-5分钟。1:2。3天内可长满。;生长特性:贴壁生长;形态特性:上皮样;相关产品有:MCM Cells、EAhy926 Cells、MDAMB435S Cells
LO2 Cells;背景说明:详见相关文献介绍;传代方法:1:2-1:3传代;每周换液2-3次。;生长特性:贴壁或悬浮,详见产品说明书部分;形态特性:详见产品说明书;相关产品有:IOSE 29 Cells、NR 8383 Cells、Hs 695T Cells
SNU-423 Cells;背景说明:详见相关文献介绍;传代方法:1:2传代;生长特性:贴壁生长;形态特性:上皮样;相关产品有:CNE-2 Cells、SRA01/04 (HLE) Cells、CTLA4 Ig-24 Cells
Ly19 Cells;背景说明:弥漫大B淋巴瘤;女性;传代方法:1:2-1:3传代;每周换液2-3次。;生长特性:悬浮;形态特性:详见产品说明书;相关产品有:CRFK Cells、SuperTube Cells、NB9 Cells
SW579 Cells;背景说明:在裸鼠中成瘤(产生三级恶性纺锤状巨细胞瘤)。 ;传代方法:1:2传代;生长特性:贴壁生长;形态特性:上皮细胞样;相关产品有:Human ErythroLeukemia Cells、HS766T Cells、Ej138 Cells
HyCyte Bewo KO-hABCG2 Cells(拥有STR基因鉴定图谱)
LB2784-MEL Cells(拥有STR基因鉴定图谱)
MyLa 1928 Cells(拥有STR基因鉴定图谱)
OUMS-22 [1972] Cells(拥有STR基因鉴定图谱)
RPMI-7722 Cells(拥有STR基因鉴定图谱)
Ubigene A-549 CACNG4 KO Cells(拥有STR基因鉴定图谱)
UOFS-CT-1 Cells(拥有STR基因鉴定图谱)
HAP1 USP15 (-) 3 Cells(拥有STR基因鉴定图谱)
PECAPJ34 Cells;背景说明:详见相关文献介绍;传代方法:1:2传代;生长特性:贴壁生长;形态特性:上皮样;相关产品有:BT Cells、C518 Cells、Hs611T Cells
SRA 01/04 Cells;背景说明:晶状体;上皮细胞;SV40转化;男性;传代方法:1:2-1:3传代;每周换液2-3次。;生长特性:贴壁;形态特性:详见产品说明书;相关产品有:HN4 Cells、CEM-0 Cells、MC38 Cells
253J B-V Cells;背景说明:膀胱癌;淋巴结转移;男性;传代方法:1:2-1:3传代;每周换液2-3次。;生长特性:贴壁;形态特性:详见产品说明书;相关产品有:MNNG/HOS Cl #5 Cells、HEC-1A Cells、H838 Cells
BIC1 Cells;背景说明:食管腺癌;男性;传代方法:1:2-1:3传代;每周换液2-3次。;生长特性:贴壁;形态特性:详见产品说明书;相关产品有:NCI-H1048 Cells、TR 146 Cells、AHH-1 Cells
COLO-699 Cells;背景说明:详见相关文献介绍;传代方法:1:2-1:3传代;每周换液2-3次。;生长特性:贴壁或悬浮,详见产品说明书部分;形态特性:详见产品说明书;相关产品有:LI7 Cells、CMT-64 Cells、BSC-1 Cells
COLO-699 Cells;背景说明:详见相关文献介绍;传代方法:1:2-1:3传代;每周换液2-3次。;生长特性:贴壁或悬浮,详见产品说明书部分;形态特性:详见产品说明书;相关产品有:LI7 Cells、CMT-64 Cells、BSC-1 Cells
TE354.T Cells;背景说明:详见相关文献介绍;传代方法:1:2传代;生长特性:贴壁生长 ;形态特性:详见产品说明书;相关产品有:S.B. Cells、HCC44 Cells、RS1 Cells
Medical University of Graz-Chordoma 1 Cells;背景说明:骶骨脊索瘤;女性;传代方法:1:2-1:3传代;每周换液2-3次。;生长特性:贴壁;形态特性:详见产品说明书;相关产品有:HEH2 Cells、CA46 Cells、B95-8 Cells
Gejiu Lung Carcinoma-82 Cells;背景说明:详见相关文献介绍;传代方法:1:2-1:3传代;每周换液2-3次。;生长特性:贴壁或悬浮,详见产品说明书部分;形态特性:详见产品说明书;相关产品有:NCI-H1395 Cells、87 MG Cells、OCILY-3 Cells
H-2108 Cells;背景说明:详见相关文献介绍;传代方法:1:2-1:3传代;每周换液2-3次。;生长特性:贴壁或悬浮,详见产品说明书部分;形态特性:详见产品说明书;相关产品有:HEK;293 Cells、KM932 Cells、HS578 Cells
Cor L51 Cells;背景说明:详见相关文献介绍;传代方法:1:2-1:3传代;每周换液2-3次。;生长特性:贴壁或悬浮,详见产品说明书部分;形态特性:详见产品说明书;相关产品有:NU-GC-3 Cells、8305C Cells、MeSoTheliOma-211H Cells
CORL23 Cells;背景说明:详见相关文献介绍;传代方法:1:2-1:3传代;每周换液2-3次。;生长特性:贴壁或悬浮,详见产品说明书部分;形态特性:详见产品说明书;相关产品有:DoTc2 Cells、Madin Darby Bovine Kidney Cells、RF/6A Cells
HCT/FU Cells;背景说明:详见相关文献介绍;传代方法:1:2-1:3传代;每周换液2-3次。;生长特性:贴壁或悬浮,详见产品说明书部分;形态特性:详见产品说明书;相关产品有:Hs 27 Cells、Panc-1-P Cells、HUVSMC Cells
C3H10T1-2 Cells;背景说明:详见相关文献介绍;传代方法:1:2-1:3传代;每周换液2-3次。;生长特性:贴壁或悬浮,详见产品说明书部分;形态特性:详见产品说明书;相关产品有:V79-1 Cells、BT 325 Cells、Stanford University-Diffuse Histiocytic Lymphoma-5 Cells
YD-15 Cells;背景说明:舌鳞癌;男性;传代方法:1:2-1:3传代;每周换液2-3次。;生长特性:贴壁;形态特性:详见产品说明书;相关产品有:Ketr3 Cells、NSC34 Cells、Panc-10.05 Cells
TC-1/dB2m Cells(拥有STR基因鉴定图谱)
CEM/0 Cells;背景说明:G.E. Foley 等人建立了类淋巴母细胞细胞株CCRF-CEM。 细胞是1964年11月从一位四岁白人女性急性淋巴细胞白血病患者的外周血白血球衣中得到。此细胞系从香港收集而来。;传代方法:1:2传代。3天内可长满。;生长特性:悬浮生长;形态特性:淋巴母细胞样;相关产品有:NCI-H1734 Cells、GM01232E Cells、NTera-2D1 Cells
Cates 1B Cells;背景说明:详见相关文献介绍;传代方法:1:2-1:3传代;每周换液2-3次。;生长特性:贴壁或悬浮,详见产品说明书部分;形态特性:详见产品说明书;相关产品有:KP2 Cells、67NR Cells、A549 Cells
H-2342 Cells;背景说明:详见相关文献介绍;传代方法:1:2-1:6传代 ;生长特性:贴壁生长;形态特性:上皮样;相关产品有:HCT116/L Cells、LoVo Cells、H1563 Cells
B16 melanoma Cells;背景说明:该细胞源于C57BL/6J小鼠黑色素瘤,可以产生黑色素,同基因小鼠体内移植可成瘤;传代方法:1:3传代,2-3天换液一次;生长特性:贴壁生长;形态特性:梭形;相关产品有:As-PC1 Cells、End1/E6E7 Cells、H889 Cells
XuanWei Lung Cancer-05 Cells;背景说明:肺癌;女性;传代方法:1:2-1:3传代;每周换液2-3次。;生长特性:贴壁;形态特性:详见产品说明书;相关产品有:GM 2132 Cells、MFE 280 Cells、R D Cells
┈订┈购┈热┈线:1┈5┈8┈0┈0┈5┈7┈6┈8┈6┈7【微信同号】┈Q┈Q:3┈3┈0┈7┈2┈0┈4┈2┈7┈1;
T2 Cells;背景说明:详见相关文献介绍;传代方法:1:3—1:6传代,每周换液2—3次;生长特性:悬浮生长;形态特性:淋巴母细胞样;相关产品有:HCC-38 Cells、Mel-624 Cells、Hs-695-T Cells
LN 229 Cells;背景说明:详见相关文献介绍;传代方法:1:4-1:6传代;每周换液2-3次;生长特性:贴壁生长;形态特性:上皮细胞;相关产品有:RBMVEC Cells、SUM 52PE Cells、COLO-679 Cells
SB Cells;背景说明:急性T淋巴细胞白血病;男性;传代方法:1:2-1:3传代;每周换液2-3次。;生长特性:悬浮;形态特性:详见产品说明书;相关产品有:SU8686 Cells、KG-1 Cells、Tu 177 Cells
Eca-109 Cells;背景说明:1973年建系,来自人食管中段鳞癌组织,小块法原代培养建系。BALB/c裸鼠移植成瘤。;传代方法:1:2-1:3传代;每周换液2-3次。;生长特性:贴壁;形态特性:上皮细胞样;相关产品有:SKMEL1 Cells、F-36P Cells、HCMEC(BL12-H) Cells
MOLM-13人急性髓性白血病传代细胞|送STR图谱
TFK1 Cells;背景说明:胆管癌;男性;传代方法:1:2-1:3传代;每周换液2-3次。;生长特性:贴壁;形态特性:详见产品说明书;相关产品有:ID8 Cells、Kasumi 1 Cells、HSC Cells
SMMC-7721 Cells;背景说明:用Northernblot方法,未能检测到细胞中1.3kbLFIRE-1/HFREP-1mRNA的表达。;传代方法:1:3传代,2-3天换液一次;生长特性:贴壁生长;形态特性:上皮样;相关产品有:CCD841CoN Cells、OCILY3 Cells、MODE-K Cells
MeWo Cells;背景说明:详见相关文献介绍;传代方法:1:3-1:5传代,2-3天换液1次。;生长特性:混合生长;形态特性:成纤维细胞;相关产品有:OCI-Ly3 Cells、87 MG Cells、OS-732 Cells
NRK clone 52E Cells;背景说明:详见相关文献介绍;传代方法:1:2传代;生长特性:贴壁生长;形态特性:上皮细胞样;相关产品有:CHOS Cells、KTA-7 Cells、B-3 Cells
M14 Cells;背景说明:详见相关文献介绍;传代方法:1:3传代;生长特性:混合生长;形态特性:详见产品说明书;相关产品有:LTEP-a-2 Cells、BALL1 Cells、L cell line Cells
BayGenomics ES cell line CSE033 Cells(拥有STR基因鉴定图谱)
BayGenomics ES cell line RRT164 Cells(拥有STR基因鉴定图谱)
BayGenomics ES cell line YTC336 Cells(拥有STR基因鉴定图谱)
IX-5H9-C10 Cells(拥有STR基因鉴定图谱)
PCRP-TCF24-1D6 Cells(拥有STR基因鉴定图谱)
LO-MK-1 Cells(拥有STR基因鉴定图谱)
"
风险提示:丁香通仅作为第三方平台,为商家信息发布提供平台空间。用户咨询产品时请注意保护个人信息及财产安全,合理判断,谨慎选购商品,商家和用户对交易行为负责。对于医疗器械类产品,请先查证核实企业经营资质和医疗器械产品注册证情况。
文献和实验该产品被引用文献
"PubMed=10739008; DOI=10.1016/S0145-2126(99)00182-4
Inoue K., Kohno T., Takakura S., Hayashi Y., Mizoguchi H., Yokota J.
Frequent microsatellite instability and BAX mutations in T cell acute lymphoblastic leukemia cell lines.
Leuk. Res. 24:255-262(2000)
DOI=10.1016/B978-0-12-221970-2.50457-5
Drexler H.G.
The leukemia-lymphoma cell line factsbook.
(In book) ISBN 9780122219702; pp.1-733; Academic Press; London; United Kingdom (2001)
PubMed=11226526; DOI=10.1016/S0145-2126(00)00121-1
Inoue K., Kohno T., Takakura S., Hayashi Y., Mizoguchi H., Yokota J.
Corrigendum to: Frequent microsatellite instability and BAX mutations in T cell acute lymphoblastic leukemia cell lines Leukemia Research 24 (2000), 255-262.
Leuk. Res. 25:275-278(2001)
PubMed=12529668; DOI=10.1038/sj.leu.2402740
Quentmeier H., Reinhardt J., Zaborski M., Drexler H.G.
FLT3 mutations in acute myeloid leukemia cell lines.
Leukemia 17:120-124(2003)
PubMed=14504097; DOI=10.1182/blood-2003-02-0418
Taketani T., Taki T., Sugita K., Furuichi Y., Ishii E., Hanada R., Tsuchida M., Sugita K., Ida K., Hayashi Y.
FLT3 mutations in the activation loop of tyrosine kinase domain are frequently found in infant ALL with MLL rearrangements and pediatric ALL with hyperdiploidy.
Blood 103:1085-1088(2004)
PubMed=14671638; DOI=10.1038/sj.leu.2403236
Drexler H.G., Quentmeier H., MacLeod R.A.F.
Malignant hematopoietic cell lines: in vitro models for the study of MLL gene alterations.
Leukemia 18:227-232(2004)
PubMed=15381384; DOI=10.1016/j.cancergencyto.2004.01.029
Montemurro L., Tonelli R., Fazzina R., Martino V., Marino F., Pession A.
Identification of two MLL-MLLT3 (alias MLL-AF9) chimeric transcripts in the MOLM-13 cell line.
Cancer Genet. Cytogenet. 154:96-97(2004)
PubMed=16408098; DOI=10.1038/sj.leu.2404081
Quentmeier H., MacLeod R.A.F., Zaborski M., Drexler H.G.
JAK2 V617F tyrosine kinase mutation in cell lines derived from myeloproliferative disorders.
Leukemia 20:471-476(2006)
PubMed=22354205; DOI=10.1038/leu.2012.52; PMCID=PMC3523391
Moore A.S., Faisal A., Gonzalez de Castro D., Bavetsias V., Sun C.-B., Atrash B., Valenti M., De Haven Brandon A.K., Avery S., Mair D., Mirabella F., Swansbury J., Pearson A.D.J., Workman P., Blagg J., Raynaud F.I., Eccles S.A., Linardopoulos S.
Selective FLT3 inhibition of FLT3-ITD+ acute myeloid leukaemia resulting in secondary D835Y mutation: a model for emerging clinical resistance patterns.
Leukemia 26:1462-1470(2012)
PubMed=22460905; DOI=10.1038/nature11003; PMCID=PMC3320027
Barretina J.G., Caponigro G., Stransky N., Venkatesan K., Margolin A.A., Kim S., Wilson C.J., Lehar J., Kryukov G.V., Sonkin D., Reddy A., Liu M., Murray L., Berger M.F., Monahan J.E., Morais P., Meltzer J., Korejwa A., Jane-Valbuena J., Mapa F.A., Thibault J., Bric-Furlong E., Raman P., Shipway A., Engels I.H., Cheng J., Yu G.-Y.K., Yu J.-J., Aspesi P. Jr., de Silva M., Jagtap K., Jones M.D., Wang L., Hatton C., Palescandolo E., Gupta S., Mahan S., Sougnez C., Onofrio R.C., Liefeld T., MacConaill L.E., Winckler W., Reich M., Li N.-X., Mesirov J.P., Gabriel S.B., Getz G., Ardlie K., Chan V., Myer V.E., Weber B.L., Porter J., Warmuth M., Finan P., Harris J.L., Meyerson M.L., Golub T.R., Morrissey M.P., Sellers W.R., Schlegel R., Garraway L.A.
The Cancer Cell Line Encyclopedia enables predictive modelling of anticancer drug sensitivity.
Nature 483:603-607(2012)
PubMed=23955599; DOI=10.1038/ng.2731
Kon A., Shih L.-Y., Minamino M., Sanada M., Shiraishi Y., Nagata Y., Yoshida K.-i., Okuno Y., Bando M., Nakato R., Ishikawa S., Sato-Otsubo A., Nagae G., Nishimoto A., Haferlach C., Nowak D., Sato Y., Alpermann T., Nagasaki M., Shimamura T., Tanaka H., Chiba K., Yamamoto R., Yamaguchi T., Otsu M., Obara N., Sakata-Yanagimoto M., Nakamaki T., Ishiyama K., Nolte F., Hofmann W.-K., Miyawaki S., Chiba S., Mori H., Nakauchi H., Koeffler H.P., Aburatani H., Haferlach T., Shirahige K., Miyano S., Ogawa S.
Recurrent mutations in multiple components of the cohesin complex in myeloid neoplasms.
Nat. Genet. 45:1232-1237(2013)
PubMed=25984343; DOI=10.1038/sdata.2014.35; PMCID=PMC4432652
Cowley G.S., Weir B.A., Vazquez F., Tamayo P., Scott J.A., Rusin S., East-Seletsky A., Ali L.D., Gerath W.F.J., Pantel S.E., Lizotte P.H., Jiang G.-Z., Hsiao J., Tsherniak A., Dwinell E., Aoyama S., Okamoto M., Harrington W., Gelfand E.T., Green T.M., Tomko M.J., Gopal S., Wong T.C., Li H.-B., Howell S., Stransky N., Liefeld T., Jang D., Bistline J., Meyers B.H., Armstrong S.A., Anderson K.C., Stegmaier K., Reich M., Pellman D., Boehm J.S., Mesirov J.P., Golub T.R., Root D.E., Hahn W.C.
Parallel genome-scale loss of function screens in 216 cancer cell lines for the identification of context-specific genetic dependencies.
Sci. Data 1:140035-140035(2014)
PubMed=25877200; DOI=10.1038/nature14397
Yu M., Selvaraj S.K., Liang-Chu M.M.Y., Aghajani S., Busse M., Yuan J., Lee G., Peale F.V., Klijn C., Bourgon R., Kaminker J.S., Neve R.M.
A resource for cell line authentication, annotation and quality control.
Nature 520:307-311(2015)
PubMed=27397505; DOI=10.1016/j.cell.2016.06.017; PMCID=PMC4967469
Iorio F., Knijnenburg T.A., Vis D.J., Bignell G.R., Menden M.P., Schubert M., Aben N., Goncalves E., Barthorpe S., Lightfoot H., Cokelaer T., Greninger P., van Dyk E., Chang H., de Silva H., Heyn H., Deng X.-M., Egan R.K., Liu Q.-S., Miroo T., Mitropoulos X., Richardson L., Wang J.-H., Zhang T.-H., Moran S., Sayols S., Soleimani M., Tamborero D., Lopez-Bigas N., Ross-Macdonald P., Esteller M., Gray N.S., Haber D.A., Stratton M.R., Benes C.H., Wessels L.F.A., Saez-Rodriguez J., McDermott U., Garnett M.J.
A landscape of pharmacogenomic interactions in cancer.
Cell 166:740-754(2016)
PubMed=27750403; DOI=10.1002/gcc.22430
Palau A., Mallo M., Palomo L., Rodriguez-Hernandez I., Diesch J., Campos D., Granada I., Junca J., Drexler H.G., Sole F., Buschbeck M.
Immunophenotypic, cytogenetic, and mutational characterization of cell lines derived from myelodysplastic syndrome patients after progression to acute myeloid leukemia.
Genes Chromosomes Cancer 56:243-252(2017)
PubMed=28052028; DOI=10.18632/oncotarget.14342; PMCID=PMC5355301
Hur E.-H., Jung S.-H., Goo B.-K., Moon J., Choi Y., Choi D.R., Chung Y.-J., Lee J.-H.
Establishment and characterization of hypomethylating agent-resistant cell lines, MOLM/AZA-1 and MOLM/DEC-5.
Oncotarget 8:11748-11762(2017)
PubMed=28109323; DOI=10.1186/s13045-017-0396-0; PMCID=PMC5251306
Masetti R., Bertuccio S.N., Astolfi A., Chiarini F., Lonetti A., Indio V., De Luca M., Bandini J., Serravalle S., Franzoni M., Pigazzi M., Martelli A.M., Basso G., Locatelli F., Pession A.
Hh/Gli antagonist in acute myeloid leukemia with CBFA2T3-GLIS2 fusion gene.
J. Hematol. Oncol. 10:26.1-26.5(2017)
PubMed=28196595; DOI=10.1016/j.ccell.2017.01.005; PMCID=PMC5501076
Li J., Zhao W., Akbani R., Liu W.-B., Ju Z.-L., Ling S.-Y., Vellano C.P., Roebuck P., Yu Q.-H., Eterovic A.K., Byers L.A., Davies M.A., Deng W.-L., Gopal Y.N.V., Chen G., von Euw E.M., Slamon D.J., Conklin D., Heymach J.V., Gazdar A.F., Minna J.D., Myers J.N., Lu Y.-L., Mills G.B., Liang H.
Characterization of human cancer cell lines by reverse-phase protein arrays.
Cancer Cell 31:225-239(2017)
PubMed=29491412; DOI=10.1038/s41388-018-0150-2; PMCID=PMC5955861
Gerlach D., Tontsch-Grunt U., Baum A., Popow J., Scharn D., Hofmann M.H., Engelhardt H., Kaya O., Beck J., Schweifer N., Gerstberger T., Zuber J., Savarese F., Kraut N.
The novel BET bromodomain inhibitor BI 894999 represses super-enhancer-associated transcription and synergizes with CDK9 inhibition in AML.
Oncogene 37:2687-2701(2018)
PubMed=30285677; DOI=10.1186/s12885-018-4840-5; PMCID=PMC6167786
Tan K.-T., Ding L.-W., Sun Q.-Y., Lao Z.-T., Chien W., Ren X., Xiao J.-F., Loh X.-Y., Xu L., Lill M., Mayakonda A., Lin D.-C., Yang H.H., Koeffler H.P.
Profiling the B/T cell receptor repertoire of lymphocyte derived cell lines.
BMC Cancer 18:940.1-940.13(2018)
PubMed=30629668; DOI=10.1371/journal.pone.0210404; PMCID=PMC6328144
Uphoff C.C., Pommerenke C., Denkmann S.A., Drexler H.G.
Screening human cell lines for viral infections applying RNA-Seq data analysis.
PLoS ONE 14:E0210404-E0210404(2019)
PubMed=30894373; DOI=10.1158/0008-5472.CAN-18-2747; PMCID=PMC6445675
Dutil J., Chen Z.-H., Monteiro A.N.A., Teer J.K., Eschrich S.A.
An interactive resource to probe genetic diversity and estimated ancestry in cancer cell lines.
Cancer Res. 79:1263-1273(2019)
PubMed=31068700; DOI=10.1038/s41586-019-1186-3; PMCID=PMC6697103
Ghandi M., Huang F.W., Jane-Valbuena J., Kryukov G.V., Lo C.C., McDonald E.R. 3rd, Barretina J.G., Gelfand E.T., Bielski C.M., Li H.-X., Hu K., Andreev-Drakhlin A.Y., Kim J., Hess J.M., Haas B.J., Aguet F., Weir B.A., Rothberg M.V., Paolella B.R., Lawrence M.S., Akbani R., Lu Y.-L., Tiv H.L., Gokhale P.C., de Weck A., Mansour A.A., Oh C., Shih J., Hadi K., Rosen Y., Bistline J., Venkatesan K., Reddy A., Sonkin D., Liu M., Lehar J., Korn J.M., Porter D.A., Jones M.D., Golji J., Caponigro G., Taylor J.E., Dunning C.M., Creech A.L., Warren A.C., McFarland J.M., Zamanighomi M., Kauffmann A., Stransky N., Imielinski M., Maruvka Y.E., Cherniack A.D., Tsherniak A., Vazquez F., Jaffe J.D., Lane A.A., Weinstock D.M., Johannessen C.M., Morrissey M.P., Stegmeier F., Schlegel R., Hahn W.C., Getz G., Mills G.B., Boehm J.S., Golub T.R., Garraway L.A., Sellers W.R.
Next-generation characterization of the Cancer Cell Line Encyclopedia.
Nature 569:503-508(2019)
PubMed=31160637; DOI=10.1038/s41598-019-44491-x; PMCID=PMC6547646
Quentmeier H., Pommerenke C., Dirks W.G., Eberth S., Koeppel M., MacLeod R.A.F., Nagel S., Steube K.G., Uphoff C.C., Drexler H.G.
The LL-100 panel: 100 cell lines for blood cancer studies.
Sci. Rep. 9:8218-8218(2019)"
Inoue K., Kohno T., Takakura S., Hayashi Y., Mizoguchi H., Yokota J.
Frequent microsatellite instability and BAX mutations in T cell acute lymphoblastic leukemia cell lines.
Leuk. Res. 24:255-262(2000)
DOI=10.1016/B978-0-12-221970-2.50457-5
Drexler H.G.
The leukemia-lymphoma cell line factsbook.
(In book) ISBN 9780122219702; pp.1-733; Academic Press; London; United Kingdom (2001)
PubMed=11226526; DOI=10.1016/S0145-2126(00)00121-1
Inoue K., Kohno T., Takakura S., Hayashi Y., Mizoguchi H., Yokota J.
Corrigendum to: Frequent microsatellite instability and BAX mutations in T cell acute lymphoblastic leukemia cell lines Leukemia Research 24 (2000), 255-262.
Leuk. Res. 25:275-278(2001)
PubMed=12529668; DOI=10.1038/sj.leu.2402740
Quentmeier H., Reinhardt J., Zaborski M., Drexler H.G.
FLT3 mutations in acute myeloid leukemia cell lines.
Leukemia 17:120-124(2003)
PubMed=14504097; DOI=10.1182/blood-2003-02-0418
Taketani T., Taki T., Sugita K., Furuichi Y., Ishii E., Hanada R., Tsuchida M., Sugita K., Ida K., Hayashi Y.
FLT3 mutations in the activation loop of tyrosine kinase domain are frequently found in infant ALL with MLL rearrangements and pediatric ALL with hyperdiploidy.
Blood 103:1085-1088(2004)
PubMed=14671638; DOI=10.1038/sj.leu.2403236
Drexler H.G., Quentmeier H., MacLeod R.A.F.
Malignant hematopoietic cell lines: in vitro models for the study of MLL gene alterations.
Leukemia 18:227-232(2004)
PubMed=15381384; DOI=10.1016/j.cancergencyto.2004.01.029
Montemurro L., Tonelli R., Fazzina R., Martino V., Marino F., Pession A.
Identification of two MLL-MLLT3 (alias MLL-AF9) chimeric transcripts in the MOLM-13 cell line.
Cancer Genet. Cytogenet. 154:96-97(2004)
PubMed=16408098; DOI=10.1038/sj.leu.2404081
Quentmeier H., MacLeod R.A.F., Zaborski M., Drexler H.G.
JAK2 V617F tyrosine kinase mutation in cell lines derived from myeloproliferative disorders.
Leukemia 20:471-476(2006)
PubMed=22354205; DOI=10.1038/leu.2012.52; PMCID=PMC3523391
Moore A.S., Faisal A., Gonzalez de Castro D., Bavetsias V., Sun C.-B., Atrash B., Valenti M., De Haven Brandon A.K., Avery S., Mair D., Mirabella F., Swansbury J., Pearson A.D.J., Workman P., Blagg J., Raynaud F.I., Eccles S.A., Linardopoulos S.
Selective FLT3 inhibition of FLT3-ITD+ acute myeloid leukaemia resulting in secondary D835Y mutation: a model for emerging clinical resistance patterns.
Leukemia 26:1462-1470(2012)
PubMed=22460905; DOI=10.1038/nature11003; PMCID=PMC3320027
Barretina J.G., Caponigro G., Stransky N., Venkatesan K., Margolin A.A., Kim S., Wilson C.J., Lehar J., Kryukov G.V., Sonkin D., Reddy A., Liu M., Murray L., Berger M.F., Monahan J.E., Morais P., Meltzer J., Korejwa A., Jane-Valbuena J., Mapa F.A., Thibault J., Bric-Furlong E., Raman P., Shipway A., Engels I.H., Cheng J., Yu G.-Y.K., Yu J.-J., Aspesi P. Jr., de Silva M., Jagtap K., Jones M.D., Wang L., Hatton C., Palescandolo E., Gupta S., Mahan S., Sougnez C., Onofrio R.C., Liefeld T., MacConaill L.E., Winckler W., Reich M., Li N.-X., Mesirov J.P., Gabriel S.B., Getz G., Ardlie K., Chan V., Myer V.E., Weber B.L., Porter J., Warmuth M., Finan P., Harris J.L., Meyerson M.L., Golub T.R., Morrissey M.P., Sellers W.R., Schlegel R., Garraway L.A.
The Cancer Cell Line Encyclopedia enables predictive modelling of anticancer drug sensitivity.
Nature 483:603-607(2012)
PubMed=23955599; DOI=10.1038/ng.2731
Kon A., Shih L.-Y., Minamino M., Sanada M., Shiraishi Y., Nagata Y., Yoshida K.-i., Okuno Y., Bando M., Nakato R., Ishikawa S., Sato-Otsubo A., Nagae G., Nishimoto A., Haferlach C., Nowak D., Sato Y., Alpermann T., Nagasaki M., Shimamura T., Tanaka H., Chiba K., Yamamoto R., Yamaguchi T., Otsu M., Obara N., Sakata-Yanagimoto M., Nakamaki T., Ishiyama K., Nolte F., Hofmann W.-K., Miyawaki S., Chiba S., Mori H., Nakauchi H., Koeffler H.P., Aburatani H., Haferlach T., Shirahige K., Miyano S., Ogawa S.
Recurrent mutations in multiple components of the cohesin complex in myeloid neoplasms.
Nat. Genet. 45:1232-1237(2013)
PubMed=25984343; DOI=10.1038/sdata.2014.35; PMCID=PMC4432652
Cowley G.S., Weir B.A., Vazquez F., Tamayo P., Scott J.A., Rusin S., East-Seletsky A., Ali L.D., Gerath W.F.J., Pantel S.E., Lizotte P.H., Jiang G.-Z., Hsiao J., Tsherniak A., Dwinell E., Aoyama S., Okamoto M., Harrington W., Gelfand E.T., Green T.M., Tomko M.J., Gopal S., Wong T.C., Li H.-B., Howell S., Stransky N., Liefeld T., Jang D., Bistline J., Meyers B.H., Armstrong S.A., Anderson K.C., Stegmaier K., Reich M., Pellman D., Boehm J.S., Mesirov J.P., Golub T.R., Root D.E., Hahn W.C.
Parallel genome-scale loss of function screens in 216 cancer cell lines for the identification of context-specific genetic dependencies.
Sci. Data 1:140035-140035(2014)
PubMed=25877200; DOI=10.1038/nature14397
Yu M., Selvaraj S.K., Liang-Chu M.M.Y., Aghajani S., Busse M., Yuan J., Lee G., Peale F.V., Klijn C., Bourgon R., Kaminker J.S., Neve R.M.
A resource for cell line authentication, annotation and quality control.
Nature 520:307-311(2015)
PubMed=27397505; DOI=10.1016/j.cell.2016.06.017; PMCID=PMC4967469
Iorio F., Knijnenburg T.A., Vis D.J., Bignell G.R., Menden M.P., Schubert M., Aben N., Goncalves E., Barthorpe S., Lightfoot H., Cokelaer T., Greninger P., van Dyk E., Chang H., de Silva H., Heyn H., Deng X.-M., Egan R.K., Liu Q.-S., Miroo T., Mitropoulos X., Richardson L., Wang J.-H., Zhang T.-H., Moran S., Sayols S., Soleimani M., Tamborero D., Lopez-Bigas N., Ross-Macdonald P., Esteller M., Gray N.S., Haber D.A., Stratton M.R., Benes C.H., Wessels L.F.A., Saez-Rodriguez J., McDermott U., Garnett M.J.
A landscape of pharmacogenomic interactions in cancer.
Cell 166:740-754(2016)
PubMed=27750403; DOI=10.1002/gcc.22430
Palau A., Mallo M., Palomo L., Rodriguez-Hernandez I., Diesch J., Campos D., Granada I., Junca J., Drexler H.G., Sole F., Buschbeck M.
Immunophenotypic, cytogenetic, and mutational characterization of cell lines derived from myelodysplastic syndrome patients after progression to acute myeloid leukemia.
Genes Chromosomes Cancer 56:243-252(2017)
PubMed=28052028; DOI=10.18632/oncotarget.14342; PMCID=PMC5355301
Hur E.-H., Jung S.-H., Goo B.-K., Moon J., Choi Y., Choi D.R., Chung Y.-J., Lee J.-H.
Establishment and characterization of hypomethylating agent-resistant cell lines, MOLM/AZA-1 and MOLM/DEC-5.
Oncotarget 8:11748-11762(2017)
PubMed=28109323; DOI=10.1186/s13045-017-0396-0; PMCID=PMC5251306
Masetti R., Bertuccio S.N., Astolfi A., Chiarini F., Lonetti A., Indio V., De Luca M., Bandini J., Serravalle S., Franzoni M., Pigazzi M., Martelli A.M., Basso G., Locatelli F., Pession A.
Hh/Gli antagonist in acute myeloid leukemia with CBFA2T3-GLIS2 fusion gene.
J. Hematol. Oncol. 10:26.1-26.5(2017)
PubMed=28196595; DOI=10.1016/j.ccell.2017.01.005; PMCID=PMC5501076
Li J., Zhao W., Akbani R., Liu W.-B., Ju Z.-L., Ling S.-Y., Vellano C.P., Roebuck P., Yu Q.-H., Eterovic A.K., Byers L.A., Davies M.A., Deng W.-L., Gopal Y.N.V., Chen G., von Euw E.M., Slamon D.J., Conklin D., Heymach J.V., Gazdar A.F., Minna J.D., Myers J.N., Lu Y.-L., Mills G.B., Liang H.
Characterization of human cancer cell lines by reverse-phase protein arrays.
Cancer Cell 31:225-239(2017)
PubMed=29491412; DOI=10.1038/s41388-018-0150-2; PMCID=PMC5955861
Gerlach D., Tontsch-Grunt U., Baum A., Popow J., Scharn D., Hofmann M.H., Engelhardt H., Kaya O., Beck J., Schweifer N., Gerstberger T., Zuber J., Savarese F., Kraut N.
The novel BET bromodomain inhibitor BI 894999 represses super-enhancer-associated transcription and synergizes with CDK9 inhibition in AML.
Oncogene 37:2687-2701(2018)
PubMed=30285677; DOI=10.1186/s12885-018-4840-5; PMCID=PMC6167786
Tan K.-T., Ding L.-W., Sun Q.-Y., Lao Z.-T., Chien W., Ren X., Xiao J.-F., Loh X.-Y., Xu L., Lill M., Mayakonda A., Lin D.-C., Yang H.H., Koeffler H.P.
Profiling the B/T cell receptor repertoire of lymphocyte derived cell lines.
BMC Cancer 18:940.1-940.13(2018)
PubMed=30629668; DOI=10.1371/journal.pone.0210404; PMCID=PMC6328144
Uphoff C.C., Pommerenke C., Denkmann S.A., Drexler H.G.
Screening human cell lines for viral infections applying RNA-Seq data analysis.
PLoS ONE 14:E0210404-E0210404(2019)
PubMed=30894373; DOI=10.1158/0008-5472.CAN-18-2747; PMCID=PMC6445675
Dutil J., Chen Z.-H., Monteiro A.N.A., Teer J.K., Eschrich S.A.
An interactive resource to probe genetic diversity and estimated ancestry in cancer cell lines.
Cancer Res. 79:1263-1273(2019)
PubMed=31068700; DOI=10.1038/s41586-019-1186-3; PMCID=PMC6697103
Ghandi M., Huang F.W., Jane-Valbuena J., Kryukov G.V., Lo C.C., McDonald E.R. 3rd, Barretina J.G., Gelfand E.T., Bielski C.M., Li H.-X., Hu K., Andreev-Drakhlin A.Y., Kim J., Hess J.M., Haas B.J., Aguet F., Weir B.A., Rothberg M.V., Paolella B.R., Lawrence M.S., Akbani R., Lu Y.-L., Tiv H.L., Gokhale P.C., de Weck A., Mansour A.A., Oh C., Shih J., Hadi K., Rosen Y., Bistline J., Venkatesan K., Reddy A., Sonkin D., Liu M., Lehar J., Korn J.M., Porter D.A., Jones M.D., Golji J., Caponigro G., Taylor J.E., Dunning C.M., Creech A.L., Warren A.C., McFarland J.M., Zamanighomi M., Kauffmann A., Stransky N., Imielinski M., Maruvka Y.E., Cherniack A.D., Tsherniak A., Vazquez F., Jaffe J.D., Lane A.A., Weinstock D.M., Johannessen C.M., Morrissey M.P., Stegmeier F., Schlegel R., Hahn W.C., Getz G., Mills G.B., Boehm J.S., Golub T.R., Garraway L.A., Sellers W.R.
Next-generation characterization of the Cancer Cell Line Encyclopedia.
Nature 569:503-508(2019)
PubMed=31160637; DOI=10.1038/s41598-019-44491-x; PMCID=PMC6547646
Quentmeier H., Pommerenke C., Dirks W.G., Eberth S., Koeppel M., MacLeod R.A.F., Nagel S., Steube K.G., Uphoff C.C., Drexler H.G.
The LL-100 panel: 100 cell lines for blood cancer studies.
Sci. Rep. 9:8218-8218(2019)"
文献支持
MOLM-13人急性髓性白血病传代细胞|送STR图谱
¥850 - 2150